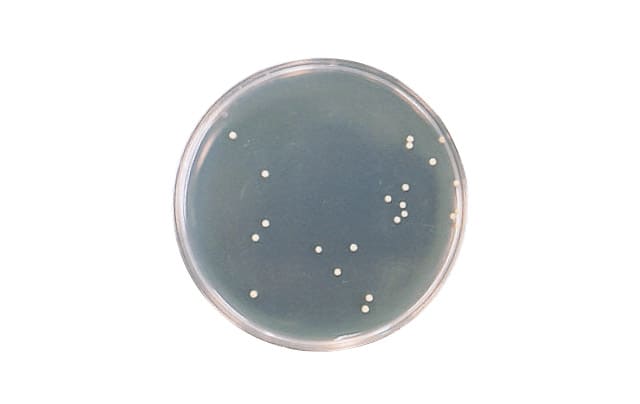
LES | シャンソン化粧品

シャンソンLesクレンジング他 LES | シャンソン化粧品
(4096件)
Pontaパス特典
サンキュー配送
7598円(税込)
76ポイント(1%)
Pontaパス会員ならさらに+1%ポイント還元!
送料
(
)
4082
配送情報
お届け予定日:2026.05.04 9:9までにお届け
※一部地域・離島につきましては、表示のお届け予定日期間内にお届けできない場合があります。
ロットナンバー
8504141898
お買い物の前にチェック!

Pontaパス会員なら
ポイント+1%
ポイント+1%
商品説明

セルキスフォームLesクレンジング2本UVクリーム
| カテゴリー: | コスメ・美容>>>スキンケア・基礎化粧品>>>洗顔料 |
|---|---|
| 商品の状態: | 新品、未使用","新品で購入し、一度も使用していない |
| 配送料の負担: | 送料込み(出品者負担) |
| 配送の方法: | 佐川急便/日本郵便 |
| 発送元の地域: | 未定 |
| 発送までの日数: | 1~2日で発送 |
レビュー
商品の評価:




 4.4点(4096件)
4.4点(4096件)
- ヒゲ親父0228
- 1本使用し終わったので再度レビューーーーーーーーーー! 顔と頭皮と背中にニキビの出来やすい夫。以前ラベンダーを使ってみて、私には脱脂力が強いわぁ・・・(乾燥肌)と思ってたのを思い出して、マジックソープを何年かぶりに購入。 シトラスオレンジすごくさわやか!誰でも好みそうな香りです!もともと精油の中でもオレンジは日本人は大概の人に受け入れられる香りですもんね!季節を問わない香り。 ・・・で、肝心なオットの使用感ですが。最初はボディソープとして。「おお、洗いあがりがイヤにサッパリして気持ちいい!」→『洗顔もイケる!』→『なんだかニキビが減ってきた!』→『髪もコレで洗うことにした!(つまりは全身)イイ!』・・・結局、全身オットはコレを使用しており、なんとニキビが減ってきたというのですよ。特に頭皮! 私は元々が乾燥してるので、少し薄めに。ボディのみですが、コレを使い始めたら普通のボディソープが無理になります・・・なんだかヌルヌルして。ぼちぼち顔にも使いだしましたが、イイかんじです!季節も幸いしたかな? ただ、オットのように洗髪は出来ません・・・髪がギシギシ。ハードル高いなぁぁぁぁ! 全般に我が家のお気に入りとなり、次に購入は・・・オットのリクエストで、ニキビに効果がありそうな『ティーツリー!』です。
- pappy☆
- 個別に、ミントオイル(ハッカ)を足したら、これは・・・最強ですね。 夏場はどうしても熱くなってくるので、ひんやり感を期待して購入してみました。 ちなみに、ミントは今回初めて。 好みで、そうやって、オイルを足してみるのも香りが浴室内に広がって バスタイムを満喫できると思いますよ。
- komari2222
- プチプチで梱包してゆうパック用の紙袋に入れて送られてきました。商品は無事でした。
- jessy19765-5
- 始めて購入しましたが、泡立ちが良く、洗い流したあとが爽快!
- ゆりな(*^_^*)
- よくもなく悪くもなくといったところでしょうか?普段から使う洗顔フォームですのでコストパフォーマンスのよい商品がいいですね。
- yumimatu
- 毎日利用しています。アレルギーテスト済みなので安心して利用しています。 250457-20120603-0869992208
- りおママ☆♪
- 価格の安さにお試しで購入してみました。リピで購入できれば良いのですが・・・!
- matsu08小隊
- 嫁に頼まれて購入しました。 市販の3割引かつポイントがつくということで妻も私も大満足です。 化粧品なんて、電化製品と同じでものはどこで購入しても変わらないのだから、安ければ安いほどいいに決まってます。 リピします。
- bluedragon
- とても泡立ちがよく、洗い終わった後スースーするので今の季節には持ってこいだと思います。
- sei6391
- 可もなく、不可もなくといった印象です。 ただウォーターローションの使用感は抜群なので、ついついセットで買ってしまいます。
- chiachamove
- この洗顔フォームは初めて使います。 優しい香りで、泡立ちも良く(泡立てネットを使ってますが)、 洗顔後もつっぱることなく、気に入っています。
すべて見る
お店の情報
7,367
連絡・応対
4.3
配送スピード
4.3
梱包
4.3